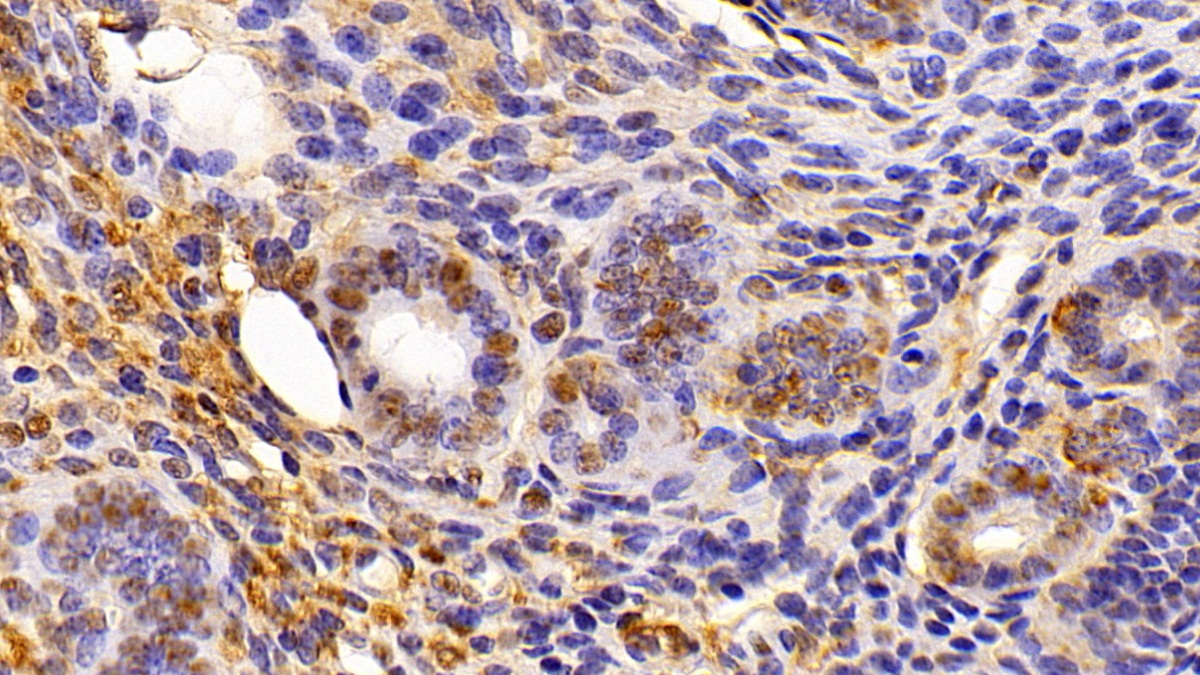
Polyclonal Antibody to High Mobility Group Protein 1 (HMGB1)

【高遷移率族蛋白1檢測】High Mobility Group Protein 1 (HMGB1) 分析商品
High Mobility Group Protein 1 (HMGB1) 高遷移率族蛋白1
HMGB1高遷移率族蛋白1是35年前發現的存在於真核細胞核內的非組蛋白染色體結合蛋白,因其在聚丙烯酞胺凝膠電泳(PAGE)中遷移速度快而得名.HMGB1是一個含有215個氨基酸殘基 的單鏈多肽,高度保守,N端富含帶正電荷的賴氨酸,C末端富含帶負電荷的天門冬氨酸和谷氨酸,又稱酸性尾巴,分子量約為24894 Da。DNA結合蛋白與染色質結合併具有 bend DNA的能力。 優先結合單鏈DNA( single-stranded DNA)。 通過充當RAG複合物的輔因子參與V(D)J重組。 通過在保守重組信號序列(RSS)的23bp間隔區刺激切割和RAG蛋白結合作用。 肝素結合蛋白,其在發育中的細胞中延伸neurite-type cytoplasmic processes神經突類型的細胞質過程中扮演重要作用。 Uniprot:P09429 NCBI:NM_002128 NP_002119.1 Cloud clone提供一系列高遷移率族蛋白1(HMGB1)多株抗體、高遷移率族蛋白1(HMGB1)重組蛋白、高遷移率族蛋白1檢測試劑盒 , 提供HMGB1完整之分析。
Recombinant High Mobility Group Protein 1 (HMGB1) 重組高遷移率族蛋白1(HMGB1)重組蛋白 | 貨號RPA399Mu01
產品介紹: Cloud clone提供原核及真核生物表現之重組蛋白系列商品;其中Recombinant High Mobility Group Protein 1 (HMGB1) 重組蛋白。Organism Species為Mus musculus (Mouse)。來源為Prokaryotic expression; HOST來源為E.coli。預測分子量為26.2kDa; Accurate Molecular Mass 33kDa (Analysis of differences refer to the manual); Met1~Glu215 with N-terminal His Tag。內毒素<1.0EU per 1µg (LAL method偵測); 細胞表現位置Nucleus, Cytoplasm, Chromosome。Isoelectric Point5.6。純度> 90%,提供凍乾型式包裝。可應用於Positive Control; Immunogen; SDS-PAGE; WB.等不同研究。

蛋白質保存型式
蛋白質溶於PBS, pH7.4, containing 0.01% SKL, 1mM DTT, 5% Trehalose and Proclin300. 為冷凍乾燥包裝。使用前Reconstitute in PBS (pH7.4) to a concentration of 0.1-1.0 mg/mL避免vortex. 短期保存Store at 2-8°C for one month.分裝-80°C長期12 個月。請避免反覆冷凍解凍。

產品附贈Positive control | Loading抗體 | SABC Kit (三擇一)
Polyclonal Antibody to High Mobility Group Protein 1 (HMGB1)多株抗體 | 貨號PAA399Mu01
產品介紹: 高遷移率族蛋白1(HMGB1)多株抗體,免疫原為RPA399Mu01-Recombinant High Mobility Group Protein 1 (HMGB1)可應用於Mus musculus (Mouse) 物種。此抗體經由Antigen-specific affinity chromatography純化,保存於0.01M PBS, pH7.4, containing 0.05% Proclin-300, 50% glycerol. 抗體濃度為0.25mg/ml,最佳實驗濃度請參考操作手冊。抗體之保存: 避免反覆冷凍解凍;4°C保存;若需長期保存請貯存於-20°C。可應用於WB; IHC; ICC; IP.實驗。
Used in DAB staining on fromalin fixed paraffin-embedded Kidney tissue
相關抗體Beta-Actin單株抗體 | GAPDH多株抗體 | Lamin B1多株抗體 | Tubulin Beta單株抗體 | PCNA單株抗體 | Histone H3多株抗體
高遷移率族蛋白1多株抗體 更多單多株抗體/重組蛋白/ELISA套組
| Catalog No. | Related products for research use of Mus musculus (Mouse) Organism species | Applications (RESEARCH USE ONLY!) |
| RPA399Mu01 | Recombinant High Mobility Group Protein 1 (HMGB1) | Positive Control; Immunogen; SDS-PAGE; WB. |
| RPA399Mu02 | Recombinant High Mobility Group Protein 1 (HMGB1) | Positive Control; Immunogen; SDS-PAGE; WB. |
| PAA399Mu02 | Polyclonal Antibody to High Mobility Group Protein 1 (HMGB1) | WB; IHC; ICC; IP. |
| PAA399Mu01 | Polyclonal Antibody to High Mobility Group Protein 1 (HMGB1) | WB; IHC; ICC; IP. |
| LAA399Mu71 | Biotin-Linked Polyclonal Antibody to High Mobility Group Protein 1 (HMGB1) | WB; IHC; ICC. |
| LAA399Mu81 | FITC-Linked Polyclonal Antibody to High Mobility Group Protein 1 (HMGB1) | WB; IHC; ICC; IF. |
| SEA399Mu | ELISA Kit for High Mobility Group Protein 1 (HMGB1) | Enzyme-linked immunosorbent assay for Antigen Detection. |
Apoptosis系列抗體 (BAD)多株抗體 | (Bax)多株抗體 | (Bcl2)多株抗體 | (CASP3)多株抗體 | Angiopoietin 2 (ANGPT2)多株抗體 | (ANGPT1)多株抗體
相關商品 anti-rabbit二級抗體 | anti-mouse二級抗體 | 5分鐘快速Stripping buffer | 預染protein marker | internal control抗體 | Tag單多株抗體
Western Blot; Sample: Mouse Cerebrum lysate; Primary Ab: 1µg/ml Rabbit Anti-Mouse HMG1 Antibody
Western Blot; Sample: Human HepG2 cell lysate; Primary Ab: 1µg/ml Rabbit Anti-Mouse HMG1 Antibody